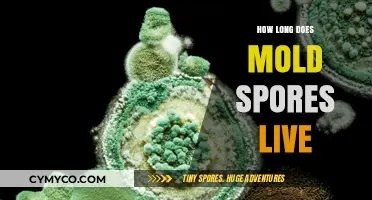
Unveiling the Lifespan of Mold Spores: A Comprehensive Guide

Hydrogen peroxide is a versatile and commonly used household chemical known for its disinfectant properties. It's often used to clean and sanitize various surfaces due to its ability to break down and remove dirt, grime, and bacteria. One of the questions frequently asked about hydrogen peroxide is whether it can effectively kill mold spores. Mold spores are a common concern in households, especially in damp areas like bathrooms and basements, and can cause health issues if inhaled. Understanding the effectiveness of hydrogen peroxide against mold spores is crucial for those looking to use it as a cleaning agent in mold-prone areas.
| Characteristics | Values |
|---|---|
| Effectiveness | Hydrogen peroxide can kill mold spores effectively. |
| Concentration | A 3% solution is commonly recommended. |
| Application Method | Can be applied directly to moldy surfaces or used in a diffuser. |
| Safety | Generally safe for use on most surfaces, but may cause skin irritation in high concentrations. |
| Environmental Impact | Breaks down into water and oxygen, making it environmentally friendly. |
| Cost | Relatively inexpensive and widely available. |
| Stability | Should be stored in a cool, dark place to maintain effectiveness. |
Explore related products
$28.99 $39.99
$7.99 $14.3
What You'll Learn
- Effectiveness: Hydrogen peroxide's efficacy in killing mold spores through oxidation
- Concentration: Optimal concentration levels of hydrogen peroxide for mold remediation
- Application Methods: Various ways to apply hydrogen peroxide to mold-infested surfaces
- Safety Precautions: Protective measures to take when using hydrogen peroxide for mold removal
- Environmental Impact: Potential effects of hydrogen peroxide on indoor air quality and surfaces

Effectiveness: Hydrogen peroxide's efficacy in killing mold spores through oxidation
Hydrogen peroxide is a powerful oxidizing agent that has been widely studied for its efficacy in killing mold spores. The mechanism by which it works is through the release of hydroxyl radicals, which are highly reactive species that can break down the cell walls of mold spores, leading to their death. Studies have shown that hydrogen peroxide is effective against a wide range of mold species, including Aspergillus, Penicillium, and Stachybotrys.
One of the key advantages of using hydrogen peroxide is its ability to penetrate deep into porous surfaces, such as wood and drywall, where mold spores often reside. This makes it an ideal choice for treating mold infestations in buildings and homes. Additionally, hydrogen peroxide is relatively inexpensive and easy to use, making it a popular choice for DIY mold remediation projects.
However, it is important to note that the effectiveness of hydrogen peroxide can vary depending on the concentration used and the duration of exposure. In general, higher concentrations of hydrogen peroxide are more effective at killing mold spores, but they can also be more corrosive and damaging to surfaces. It is therefore important to carefully follow the manufacturer's instructions when using hydrogen peroxide for mold remediation.
Another factor that can affect the efficacy of hydrogen peroxide is the presence of other substances, such as dirt and debris, which can interfere with its ability to penetrate and kill mold spores. It is therefore important to clean the affected area thoroughly before applying hydrogen peroxide.
In conclusion, hydrogen peroxide is a highly effective agent for killing mold spores through oxidation. Its ability to penetrate deep into porous surfaces and its relatively low cost make it an ideal choice for mold remediation projects. However, it is important to use it carefully and follow the manufacturer's instructions to ensure its effectiveness and safety.
Unlocking the Secrets: A Beginner's Guide to Liquid Culture from Spores
You may want to see also
Explore related products

Concentration: Optimal concentration levels of hydrogen peroxide for mold remediation
Hydrogen peroxide is a powerful oxidizing agent that can effectively kill mold spores. However, the concentration level of hydrogen peroxide is crucial for mold remediation. Using the wrong concentration can lead to ineffective mold removal or even damage to surfaces.
The optimal concentration of hydrogen peroxide for mold remediation is typically between 3% and 5%. This concentration range is strong enough to kill mold spores without causing damage to most surfaces. However, it's important to note that some surfaces, such as fabrics and certain types of wood, may be damaged by even this concentration range.
When using hydrogen peroxide for mold remediation, it's essential to follow proper safety precautions. Wear protective gloves, goggles, and a mask to avoid skin and eye irritation, as well as inhalation of fumes. Additionally, it's important to test the solution on a small, inconspicuous area of the surface to ensure that it doesn't cause any damage.
To effectively use hydrogen peroxide for mold remediation, follow these steps:
- Mix the appropriate concentration of hydrogen peroxide with water in a spray bottle.
- Spray the solution onto the moldy surface and allow it to sit for 10-15 minutes.
- Scrub the surface with a brush or sponge to remove the mold.
- Rinse the surface with clean water and allow it to dry completely.
Remember, hydrogen peroxide is a powerful chemical and should be used with caution. Always read and follow the manufacturer's instructions, and never mix hydrogen peroxide with other chemicals, as this can create dangerous reactions.
Unlocking Gut Health: Understanding Spore-Based Probiotics and Their Benefits
You may want to see also
Explore related products
$24.68 $26.44
$10.68 $13.87

Application Methods: Various ways to apply hydrogen peroxide to mold-infested surfaces
Hydrogen peroxide is a versatile and effective mold remediation solution that can be applied in several ways to mold-infested surfaces. One of the most common methods is to use a spray bottle to apply a solution of hydrogen peroxide and water directly to the affected area. This method allows for precise application and can be used on a variety of surfaces, including walls, ceilings, and floors.
Another effective method is to use a hydrogen peroxide gel or paste, which can be applied directly to the mold with a brush or spatula. This method is particularly useful for treating small, localized areas of mold growth. The gel or paste can be left on the surface for a period of time, allowing the hydrogen peroxide to penetrate and kill the mold spores.
For larger areas of mold infestation, it may be necessary to use a fogger or misting system to apply hydrogen peroxide. This method allows for a more uniform application of the solution and can be used to treat entire rooms or buildings. However, it is important to note that this method can be more expensive and may require specialized equipment.
Regardless of the application method, it is important to follow proper safety precautions when using hydrogen peroxide to treat mold. This includes wearing protective gloves, goggles, and a mask to avoid skin and eye irritation, as well as respiratory problems. Additionally, it is important to ensure that the area being treated is well-ventilated to prevent the buildup of hydrogen peroxide fumes.
In conclusion, hydrogen peroxide is a powerful mold remediation solution that can be applied in a variety of ways to effectively kill mold spores. By choosing the appropriate application method and following proper safety precautions, it is possible to safely and effectively treat mold infestations in a variety of settings.
Extending Mushroom Spore Lifespan: Fridge Storage Tips and Duration
You may want to see also
Explore related products
$19.99 $24.99
$21.14

Safety Precautions: Protective measures to take when using hydrogen peroxide for mold removal
Hydrogen peroxide is a powerful oxidizing agent that can effectively kill mold spores. However, it's crucial to take appropriate safety precautions when using it for mold removal to avoid potential health risks and damage to surfaces. Here are some protective measures to consider:
First, always wear personal protective equipment (PPE) when handling hydrogen peroxide for mold removal. This includes gloves, safety goggles, and a face mask to protect your skin, eyes, and respiratory system from potential irritation or damage. It's also important to work in a well-ventilated area to avoid inhaling fumes.
Second, be cautious when mixing hydrogen peroxide with other cleaning agents, as this can create harmful chemical reactions. For example, mixing hydrogen peroxide with vinegar can produce peracetic acid, a corrosive substance that can cause skin and eye irritation. Always follow the manufacturer's instructions for using hydrogen peroxide and avoid combining it with other chemicals.
Third, test the hydrogen peroxide solution on a small, inconspicuous area of the surface you plan to treat for mold removal. This will help you determine if the solution is effective and safe for use on that particular surface. Wait for at least 10-15 minutes to see if there's any adverse reaction, such as discoloration or damage.
Fourth, be aware of the potential risks associated with using hydrogen peroxide on certain surfaces. For example, high concentrations of hydrogen peroxide can damage wood, fabrics, and other porous materials. Always dilute hydrogen peroxide according to the manufacturer's instructions and avoid using it on surfaces that are sensitive to bleach or other strong oxidizing agents.
Finally, store hydrogen peroxide safely and out of reach of children and pets. It's a potent chemical that can cause serious health problems if ingested or misused. Keep it in a cool, dry place and dispose of any unused solution according to local regulations.
By following these safety precautions, you can effectively use hydrogen peroxide for mold removal while minimizing the risks to your health and the surfaces you're treating.
How Long Do Spore Prints Last: A Comprehensive Guide
You may want to see also
Explore related products

Environmental Impact: Potential effects of hydrogen peroxide on indoor air quality and surfaces
Hydrogen peroxide, a common household chemical, is often touted for its mold-killing properties. However, its use can have unintended consequences on indoor air quality and surfaces. When hydrogen peroxide is applied to mold, it can release volatile organic compounds (VOCs) into the air, potentially exacerbating respiratory issues and causing eye and throat irritation. Additionally, the chemical can leave behind a residue that may damage surfaces, particularly those made of wood, fabric, or certain plastics.
To mitigate these risks, it's essential to use hydrogen peroxide in well-ventilated areas and to follow proper application guidelines. For instance, a solution of 3% hydrogen peroxide can be effective against mold, but it should be applied with care, avoiding direct contact with skin and eyes. After application, the area should be thoroughly rinsed and dried to prevent residue buildup.
In some cases, alternative mold remediation methods may be more suitable, particularly for large infestations or for individuals with sensitivities to chemicals. Professional mold remediation services can provide safe and effective solutions, utilizing specialized equipment and techniques to eliminate mold without compromising indoor air quality or damaging surfaces.
Ultimately, while hydrogen peroxide can be a useful tool in the fight against mold, it's crucial to consider its potential environmental impacts and to use it responsibly to maintain a safe and healthy indoor environment.
Spore Syringe Shelf Life: Fridge Storage Duration Explained
You may want to see also
























![McKesson Hydrogen Peroxide 3%, 1 Gallon [Pack of 1] Topical Solution USP, First Aid Antiseptic, Oral Debriding Agent](https://m.media-amazon.com/images/I/61l+1OHcJQL._AC_UL320_.jpg)